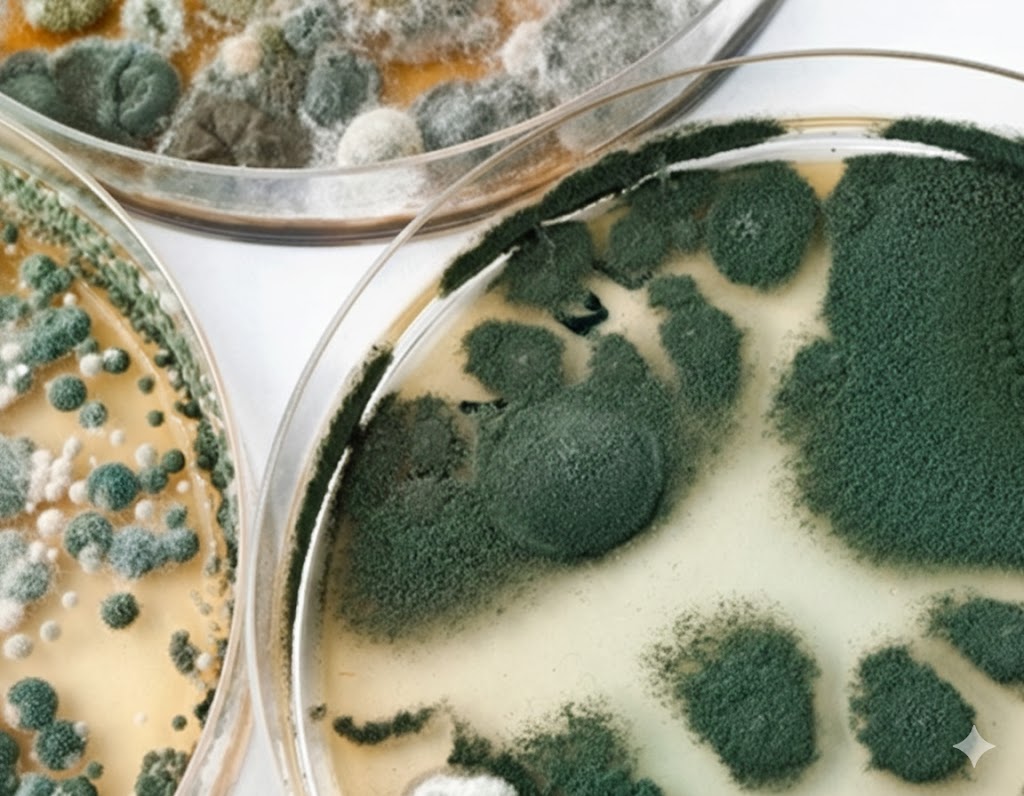

24-Hour Emergency FLOOD Services
San Diego Flood Services 858-229-7630 recognize the critical nature of water damage and flooding, providing 24/7 emergency services for water extraction, sewage spill cleanup, tear-out, drying, and full water damage restoration. Rapid response is essential to protect your property from further harm.
Our flood restoration services cater to all property types—homes, condos, businesses, high-rise, and commercial facilities. From mold remediation and asbestos removal to complete restoration, we strive to return your property to its pre-damage condition.
Expert Flood Technicians
Our team of highly trained and experienced flood technicians uses state-of-the-art tools and expertise to address any water damage restoration or flooding issue. With our prompt response and skilled approach, we effectively minimize and prevent further harm to your property and belongings.
Following a fire, flood, or plumbing failure, rapid action to dry and restore water-damaged areas can save thousands in repair costs. Our certified technicians will extract water from carpets or hardwood floors, salvaging as much material as possible to minimize losses.
San Diego Flood Services
Serving San Diego County
About us
Since 2004, San Diego Flood Services has been the go-to solution for countless emergencies, handling everything from minor spills to major residential and commercial flooding, including fire sprinkler mishaps.
We take pride in helping people in their time of such a need, and we do our best to walk you through this process with the understanding that this is likely a very stressful time for you and all involved.
things we’re great at
Frequently Asked Questions
How fast do you respond to emergencies?
We provide a 60-minute or less response anywhere in San Diego County. Emergency dispatch is available 24/7.
Are you open right now?
Yes. San Diego Flood Services is open 24/7, including nights, weekends, and holidays.
What phone number should I call?
Call 858-229-7630 for immediate local response or 760-792-7796 for San Diego County emergency service.
Do you work with insurance?
Yes. We offer direct insurance billing for water damage, flood restoration, and mold remediation.
What areas do you serve?
We serve all of San Diego County, including Oceanside, Escondido, Poway, Santee, and nearby areas.

WATER REMOVAL
Water removal must be done immediately after a flood occurs or further serious damage will occur.

PLUMBING
We fix, repair, remove, replace, and install new plumbing fixtures. Commercial or Residential.

DRAINS
We can restore flow to any backed up drain causing flooding. Plumbers are on call.
emergency flood services
San Diego Flood Services provide emergency 24 hour emergency flood services: water extraction, sewage spill clean-up and removal, drying-out, and full restoration 365 days a year.
As soon as we receive your call, we dispatch trained personnel to your site within sixty minutes or sooner seven days a week
FLOOD RESTORATION
Work could include services such as mold remediation, asbestos removal and possible reconstruction for full restoration if warranted; restoring your home or business back to its original condition. Flood restoration, renovation & remodeling services are available in San Diego County. Call with information on the services you require. In most cases, our team can dispatch trained personnel to your site within 60 minutes, 24/7, 365 days a year.
Further flood restoration work may be needed. Ongoing assessments of the damage is done within the 3 to 5 day structural drying period. The faster we can address the damage, the more items we can salvage and restore, minimizing losses and costs.
Explore Our Blog

Julian Flood Service 24/7 Water Damage Restoration
Julian Flood Service is open to take your call 24/7 –[…]
San Diego Mold Removal 888-349-2564 Testing & Inspection
San Diego Mold Removal Service. Because molds grow by digesting[…]
Services
Upon arrival, emergency water extraction is deployed, removing sewage, and water damaged building materials if needed, followed by the structural drying. We dispatch experienced San Diego emergency flood service technicians to your location right away 24/7 – 365 days a year. Further clean-up and water damage repairs may be needed and could include mold remediation, asbestos removal and possible reconstruction.
Itemized report & quotation rapidly provided, covering water extraction and drying. Immediate water extraction and structural drying and cleanup as needed. Mold stabilization and removal. Deodorizing and disinfecting. Curtains, upholstery and floor / carpet cleaning and drying. Removal of Property and Storage Services if necessary. Sewage cleanup and removal / Category 3 services.
Further Flood Damage and Restoration Assessment.
Emergency Plumbing Services, Burst Pipe Repair
Leakage Detection, Repipe & Re-Route.
Direct Insurance Billing Company
Proudly powered by WordPress
Serving San Diego County
Allied Gardens – San Diego – 4S Ranch – Barrio Logan – –Black Mountain Ranch – Camp Pendleton – Cardiff By The Sea Carlsbad – Carmel Mountain Ranch – Carmel Valley – College Area – Cortez Hill – Coronado – City Heights – Fairbanks Ranch – Chula Vista – Clairemont – Clairemont Mesa – Del Mar – El Cajon – Encinitas – Escondido – Encanto – Fallbrook –Imperial Beach – Kearny Mesa – La Mesa – La Jolla – San Marcos – Lemon Grove – Mira Mesa – Mission Valley – National City – North Park – Oceanside – Poway– Rancho Bernardo – Rancho Penasquitos – Rancho Santa Fe – San Diego – Sabre Springs – San Marcos – Service Areas – Santee – Scripps Ranch – South Bay – Solana Beach – University City – Vista – Valley Center – San Diego, Ca – MerchantCircle – Mapquest – -San Diego Blog – Restoration – Renovation – San Diego California – San Diego – San Diego County Flood Service Locations – 24-Hour Emergency Flood Services 888-349-2564 San Diego Ca – Downtown San Diego

